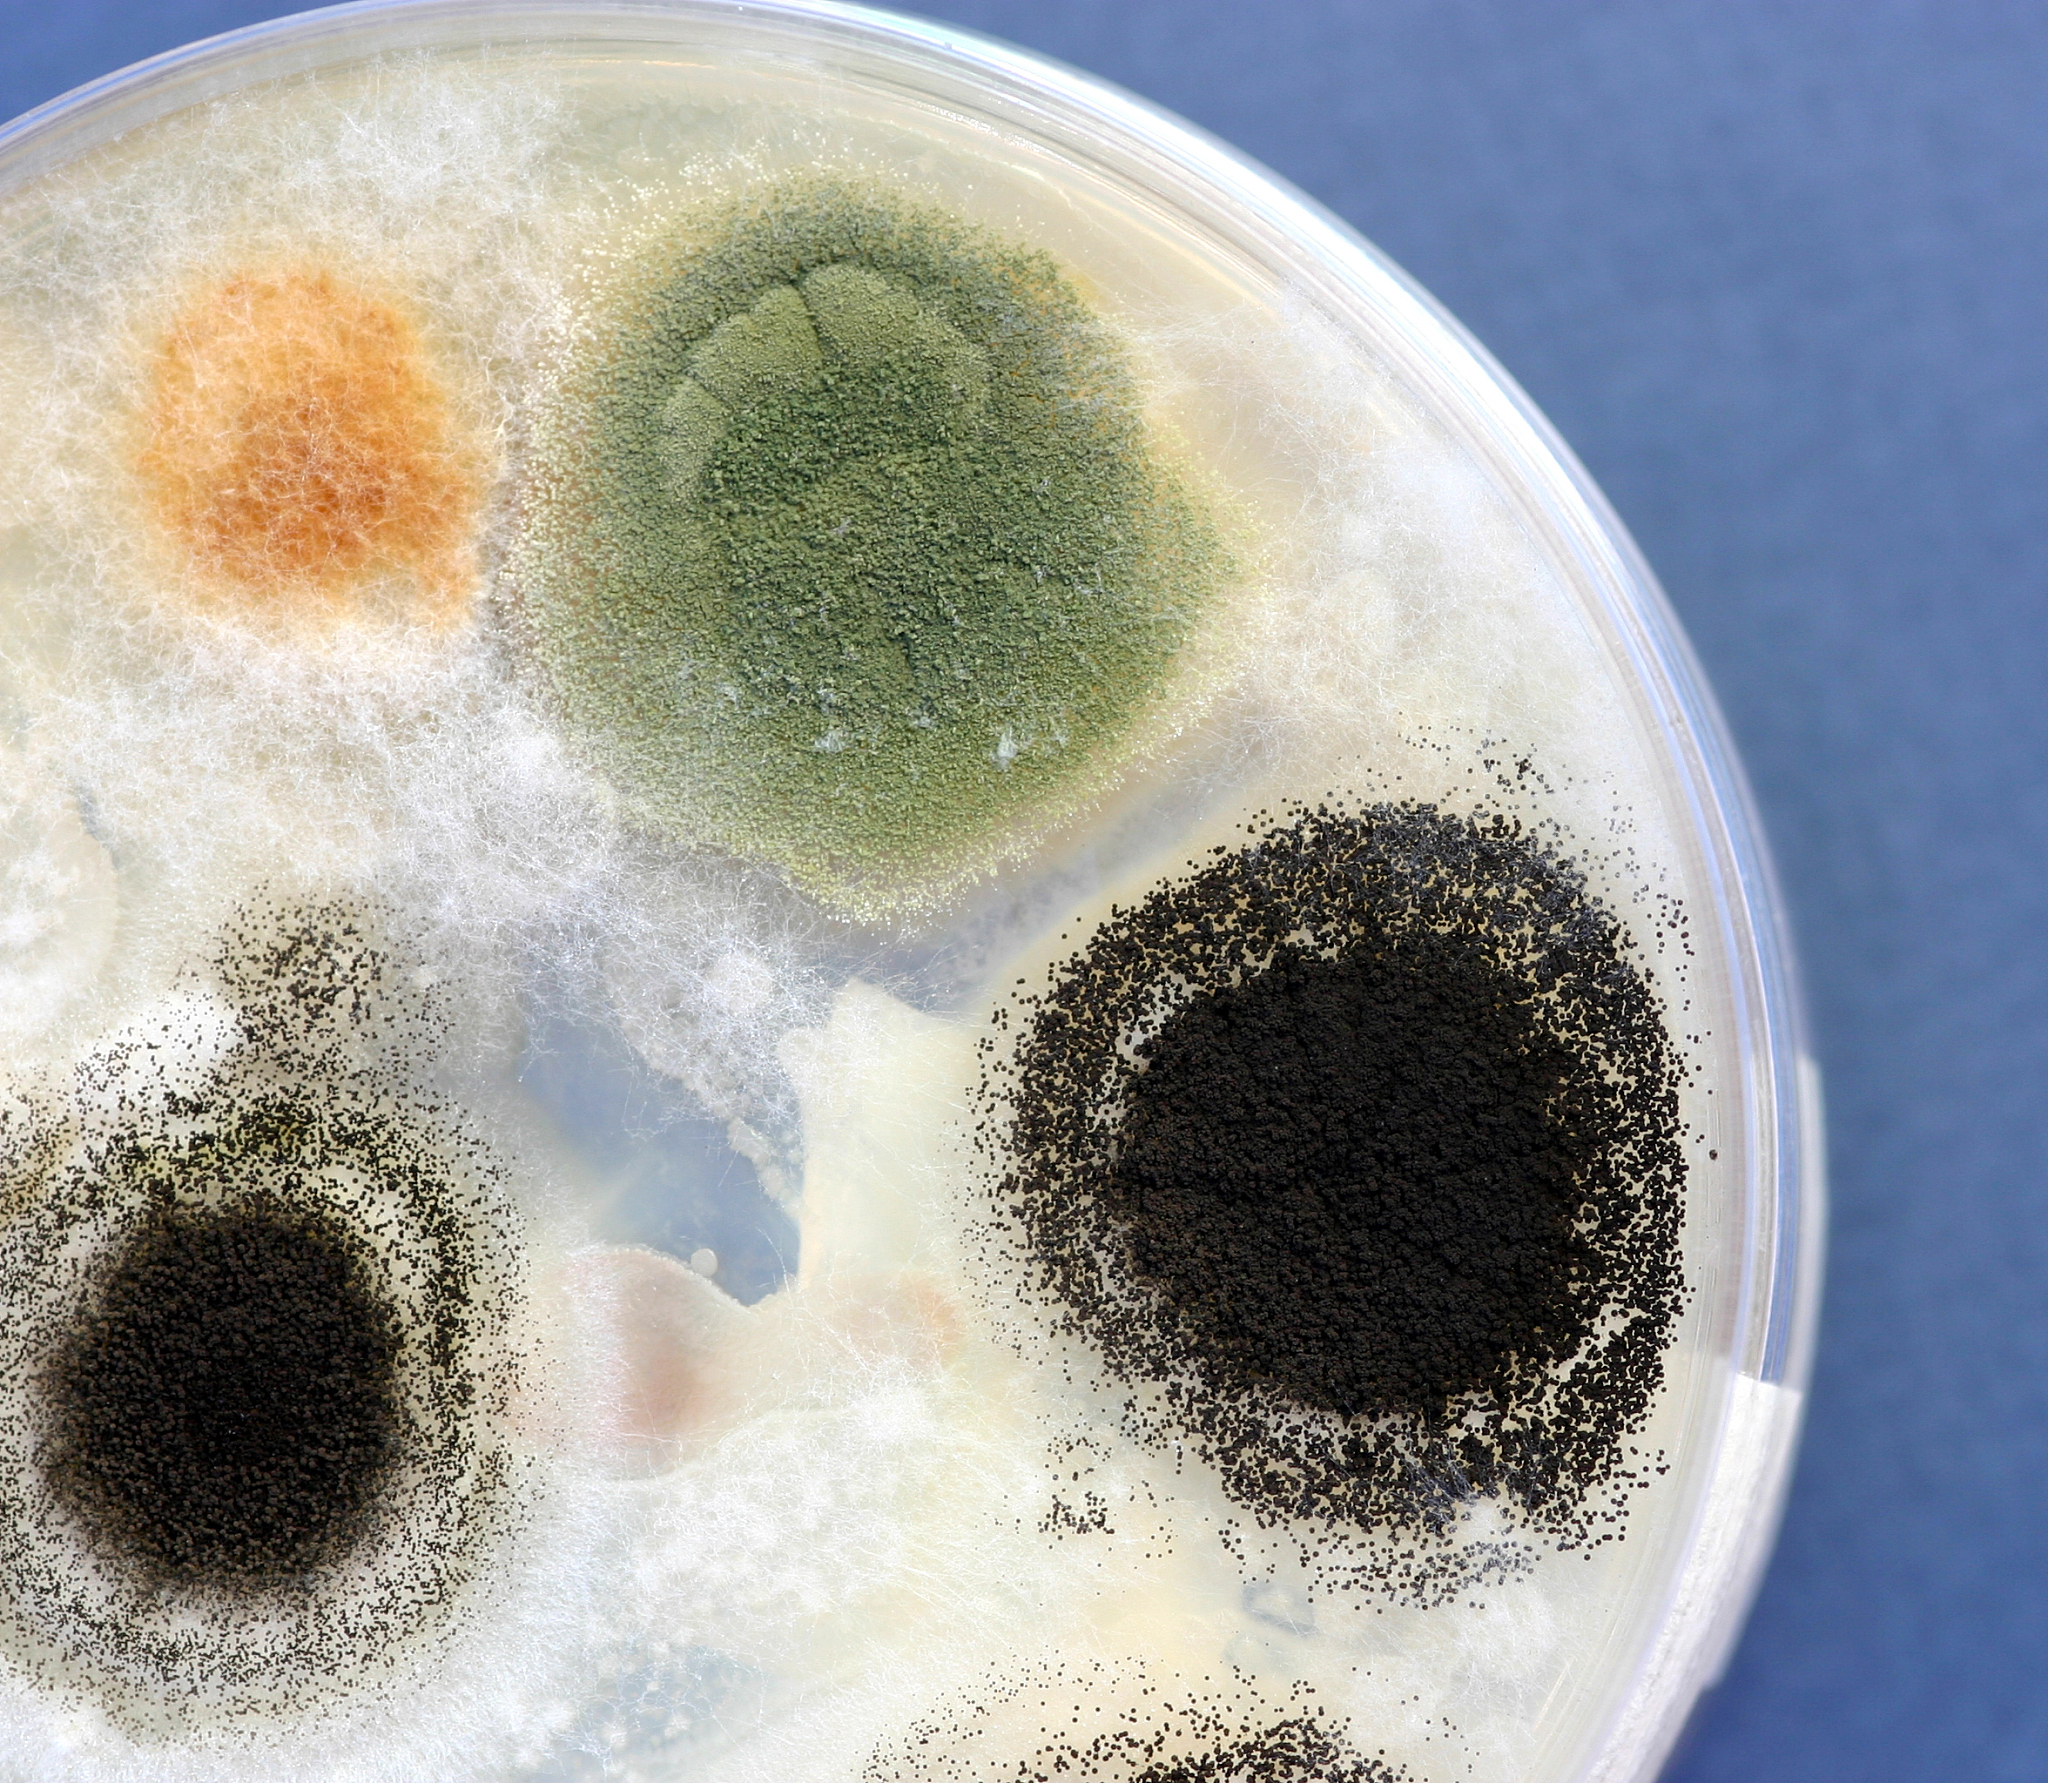
真菌和细菌的直接共培养方式请帮我举几个详细的例子精确到真菌细菌名称的

真菌和细菌的直接共培养方式请帮我举几个详细的例子精确到真菌细菌名称的
-
铜绿假单胞菌(Pseudomonas aeruginosa)和白色念珠菌(Candida albicans):这两种微生物是常见的医院感染病原菌。它们可以在共同的培养基上生长,形成复合菌落,相互作用可能会影响它们的代谢和生长。
-
绿脓杆菌(Escherichia coli)和木霉(Aspergillus niger):这两种微生物可以在培养基上直接共生。绿脓杆菌可以利用木霉产生的酸分解植物纤维素,从而促进细菌的生长。
-
真菌膜原体(Mycoplasma fungus)和链球菌(Streptococcus pyogenes):这两种微生物可以在血琼脂培养基上共同生长,形成不同的菌落形态。它们之间可能存在共生关系,但具体机制尚不清楚。
-
金黄色葡萄球菌(Staphylococcus aureus)和糠秕属霉(Fusarium oxysporum):这两种微生物可以在TSA培养基上共同生长,形成混合菌落。糠秕属霉可以分泌一些物质,可能对金黄色葡萄球菌的生长有促进作用。
-
酵母菌(Saccharomyces cerevisiae)和革兰氏阳性菌(Bacillus subtilis):这两种微生物可以在YPDA培养基上共同生长,形成混合菌落。酵母菌可以利用Bacillus subtilis产生的氨基酸等营养物质,从而促进自身的生长
原文地址: https://www.cveoy.top/t/topic/fa5Q 著作权归作者所有。请勿转载和采集!